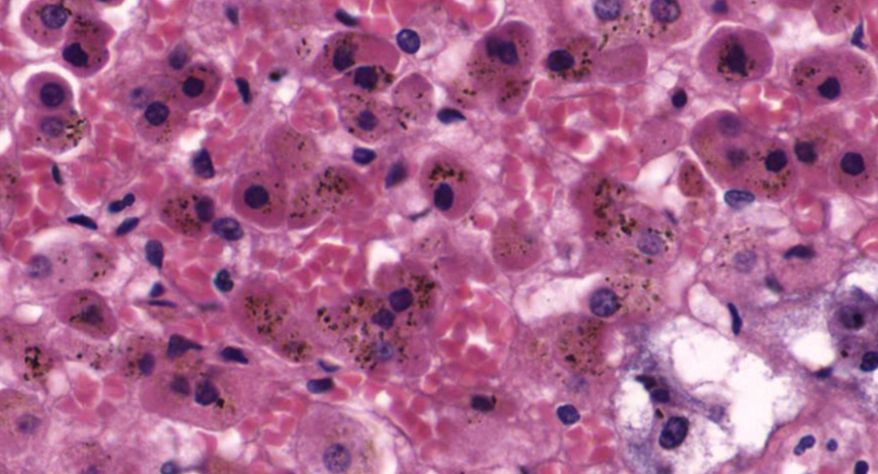
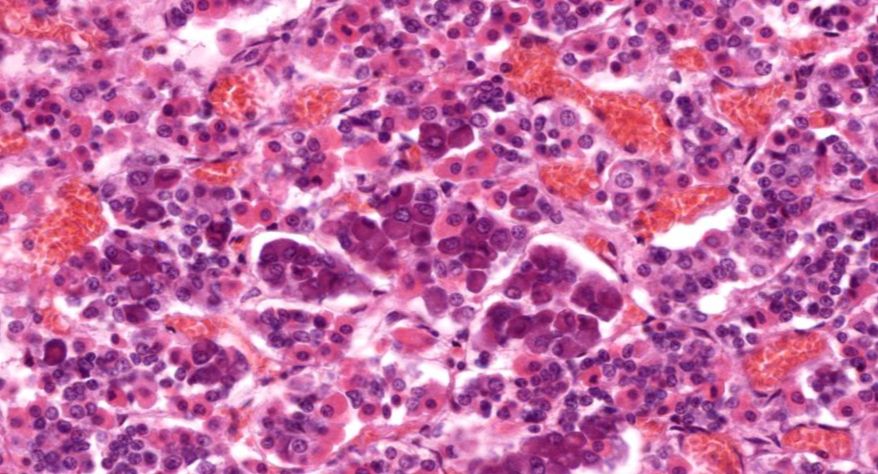
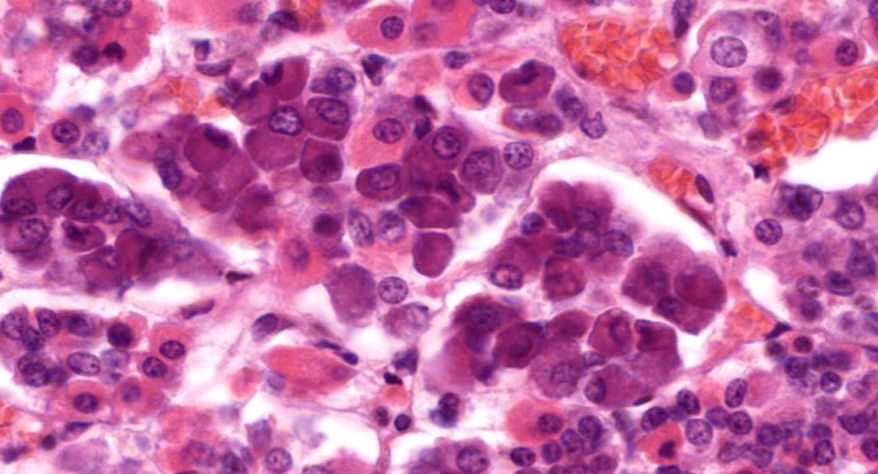
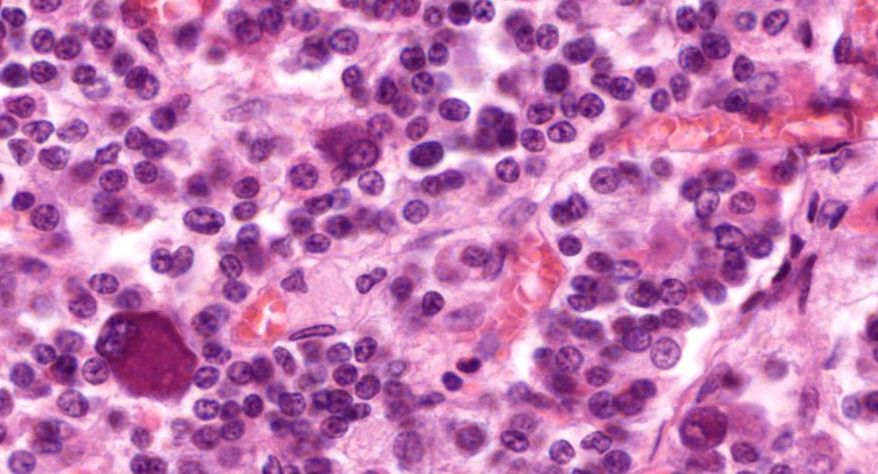

六、内分泌系统图像学习
上一节
下一节
甲状腺
1.全景图

2.滤泡

3.滤泡上皮细胞

4.胶质

5.滤泡旁细胞1

7.滤泡旁细胞2

肾上腺
1.全景图

2.被膜

3.皮质

4.球状带(10x)

5.球状带(40x)

6.束状带(10x)

7束状带(40x)

8.网状带(10x)

9.网状带(40x)

10.网状带细胞内脂褐素
11.髓质

12.嗜铬细胞

13.交感神经节细胞

14.中央静脉

垂体
嗜色细胞
2.嗜酸性细胞

3.嗜碱性细胞
4.嫌色细胞
5.中间部

6.中间部滤泡

7.神经部

8.赫林体1

9.赫林体2

10.嗜酸性细胞

11.嗜碱性细胞

12.嫌色细胞


